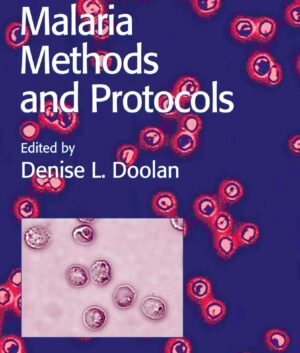
Malaria Methods and Protocols

-
- ↓ 20%
Foodborne Diseases
- Original price was: ₹18,779.₹15,023Current price is: ₹15,023.
- Add to cart
-
- ↓ 20%
Malaria Methods and Protocols
- Original price was: ₹14,084.₹11,267Current price is: ₹11,267.
- Add to cart
-
- ↓ 20%
Neuroimmune Circuits, Drugs of Abuse, and Infectious Diseases
- Original price was: ₹14,084.₹11,267Current price is: ₹11,267.
- Add to cart
Universal Academic Books Publishers & Distributors